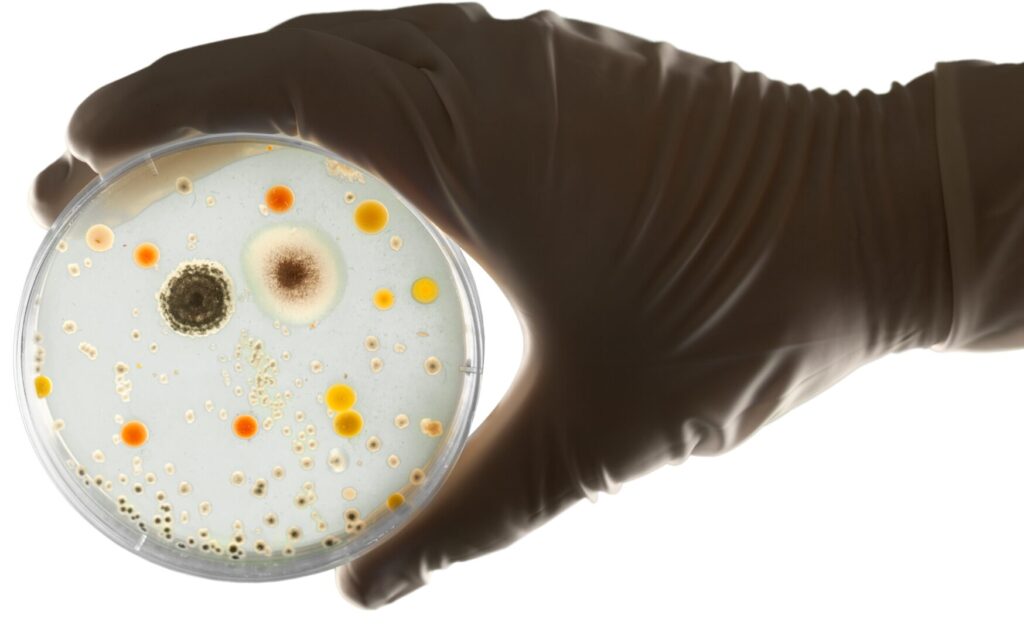

Celebrando el Día Mundial de la Energía
Desde 1949, el 14 de febrero, además de San Valentín, se celebra el Día Internacional de la Energía, con el objetivo de concienciar sobre la importancia de hacer un uso eficiente y responsable de este recurso y que sus fuentes sean más limpias y renovables.
Es importante considerar que desde que nos despertamos, estamos consumiendo energía y generando un impacto ambiental. Desde hace muchos años, se ha demostrado que el uso de combustibles fósiles tiene efectos negativos en el medio ambiente y la salud humana, y que este consumo está estrechamente relacionado con las emisiones de gases de efecto invernadero que contribuyen al Cambio Climático.
Según la Agencia Internacional de la Energía, los combustibles fósiles siguen representando más del 70% del suministro global, mientras que las energías renovables, especialmente solar y eólica, continúan creciendo y se espera que sean la principal fuente de generación de electricidad en 2025
Pero no todo vale en el uso de fuentes renovables si no que se debe realizar una transición energética correcta, justa y sostenible, debiendo ser prioritaria la REDUCCIÓN en el consumo de cualquier tipo de energía, la utilización de cubiertas de edificaciones para colocar placas solares y no ocupar suelo agrícola ni forestal, realizar estudios reales de pérdida de biodiversidad, etc.
De la energía artificial a la bioluminiscencia
La bioluminiscencia se define como la luz producida por un organismo vivo mediante una transformación de energía química a luminosa y es tan increíble que parece de película de ciencia ficción. La luz producida suele ser de color azul o azul verdoso, aunque hay casos en los que se observa de color violeta, verde amarillento y menos frecuentemente rojo.
La bioluminiscencia es una reacción química en la que la enzima luciferasa, ayuda a unir un sustrato, la luciferina, y el oxígeno, creando luz y oxiluciferina y reutilizándose la luciferasa en cada ciclo. Se trata de la conversión de energía química en energía lumínica.
Aunque en tierra la bioluminiscencia es muy poco frecuente, sí lo es en especies marinas, desde bacterias y plancton bioluminiscente, hasta calamares y peces, tanto en la superficie como en las profundidades del mar. Una de las últimas incorporaciones a la lista de más de 180 especies conocidas, es el frailecillo atlántico que emite un brillo luminoso.
Las profundidades de los océanos son completamente oscuras pero se estima que más del 75 % de los animales que viven en estas zonas producen su propia luz por lo que ésta es muy importante para su supervivencia
¡Siempre hay que ver la luz al final del túnel!
Usos de la bioluminiscencia
El conocimiento de la bioluminiscencia por parte del ser humano no es algo reciente; de hecho, ya Aristóteles, alrededor del año 350 a. C., describió la bioluminiscencia en las luciérnagas como «un tipo de luz fría».
A lo largo de la historia, diversas culturas han explorado y aprovechado este fenómeno natural, desde la navegación nocturna hasta aplicaciones en la medicina y la tecnología.
En la minería de carbón, las luciérnagas se introducían en frascos y servían para iluminar las minas, donde cualquier tipo de llama podía ser peligrosa
Este fascinante fenómeno, que convierte la energía química en luz visible, presente en diversos organismos vivos, ofrece una amplia gama de aplicaciones que van desde la ciencia básica hasta innovaciones en campos tan diversos como la investigación biotecnológica, biomédica y de ingeniería genética, así como en la comunicación, como se ilustra en los siguientes ejemplos:
- Los organismos bioluminiscentes también son útiles para la monitorización ambiental. Las enzimas luciferasas y la luciferina se utilizan como reactivos bioanalíticos y marcadores celulares en biosensores de contaminación ambiental y en prospección de drogas anticancerígenas y antibióticos, entre otras aplicaciones. En este contexto, varias luciferasas clonadas de escarabajos se están analizando actualmente para el desarrollo de biosensores y marcadores celulares.
- Los avances en tecnología permiten que las proteínas bioluminiscentes se usen para crear diagnósticos más rápidos y sensibles. Por ejemplo, en la actualidad se está desarrollando una nueva estrategia para la detección de anticuerpos contra el SARS-CoV-2 causante de la covid-19.
- Se está estudiando la creación de luz a través de organismos vivos para su uso en dispositivos electrónicos: árboles luminosos, para espacios públicos o alineaciones en autopistas, dispositivos de iluminación ambiental y señalización, etc.
- A través de la ingeniería genética, se pueden introducir genes de organismos bioluminiscentes en plantas, lo que podría ayudar a monitorear la salud de los cultivos o detectar daños.
- En la industria alimentaria, la bioluminiscencia se utiliza en pruebas de calidad para detectar la presencia de microorganismos patógenos o contaminantes en alimentos y bebidas.
- Diversos estudios experimentales actuales se centran en el hallazgo de identificadores biológicos que podrían ser aplicados en todo tipo de organismos para su control y trazabilidad (incluidos los humanos).
¡Sin ciencia no hay futuro!
Artrópodos con muchas luces
Aunque este es un campo que sigue siendo objeto de estudio, a día de hoy se cree que las funciones de la bioluminiscencia en los artrópodos incluyen:
- Atracción de pareja
- Hallar alimento
- Defensa y disuasión de depredadores
- Usarla de camuflaje para confundirse con la luz ambiental
- Caza y captura de presas
- Cortejo
- Comunicación entre individuos
- Iluminación del entorno
- Detección de su entorno
En ciertos entornos, como en las profundidades marinas, algunos artrópodos usan la bioluminiscencia para mezclarse con la luz que filtra desde la superficie, lo que les permite pasar desapercibidos ante los depredadores
Existen numerosos artrópodos bioluminiscentes, algunos de los cuales son ampliamente conocidos, como las emblemáticas luciérnagas. Sin embargo, hay otros menos populares, pero igualmente fascinantes, como las larvas de una especie de mosca y ciertos tipos de cucarachas, entre otros.
Luciérnagas
Pertenecen a la familia de los Lampyridae y son coleópteros (escarabajos). Se conocen unas 1900 especies distintas y utilizan su luz para atraer posibles parejas, como mecanismo de defensa, etc.
Sin embargo, están gravemente amenazadas por diversas causas.»
- pérdida y degradación de hábitats, y pérdida de conectividad
- contaminación lumínica
- uso de fertilizantes, plaguicidas, insecticidas y herbicidas
- el turismo de luciérnagas
Larvas de mosca
En países como Australia o Nueva Zelanda se pueden visitar unas cuevas repletas de «gusanos de luz», que son en realidad larvas de la mosca Arachnocampa flava que cuelgan de hilos pegajosos bioluminiscentes que les sirven para atraer y capturar presas: una larva hambrienta brilla más que una que acaba de comer.
Tienen pocos depredadores y su mayor peligro es la presencia humana.
Cucaracha de Ecuador
Lucihormetica luckae es una especie de cucaracha endémica de Ecuador que hace uso de la luminiscencia para fines defensivos imitando a una especie de escarabajo tóxico. El único ejemplar conocido de este insecto, fue hallado en 1939 en las faldas del volcán Tungurahua. Este volcán está activo y ha entrado varias veces en erupción, la última vez en 2010, por lo que el lugar ha sido totalmente destruido, y debido a la falta de estudios de campo recientes, no se puede confirmar con certeza su estado de conservación, pero es muy probable que ya se haya extinguido.
Existen muchos otros ejemplos fascinantes de artrópodos bioluminiscentes que no hemos mencionado, y que serán detallados durante el webinario.
¡No te lo pierdas!
Webinario: Artrópodos con luz propia
Impartido por D. Francisco José Cabrero Sañudo, Da. Sandra Grzechnik, Da. Inés Jiménez Fernández y D. Diego López– en colaboración con el Grupo de Seguimiento de Biodiversidad y el Museo de Entomología de la Universidad Complutense de Madrid-. En el seminario digital conocerás algunas especies de artrópodos que emiten luz y cuál es su función.
Antes de finalizar el directo, se reservarán unos minutos para formular preguntas y resolver dudas con los ponentes. Pero si deseáis formular vuestras consultas con antelación podéis enviarnos vuestras preguntas a infocasacampo@madrid.es y alguno de los ponentes las contestará durante el seminario.
¿Cuándo y dónde?
Tendrá lugar el viernes 14 de febrero a las 12:00 horas a través de este enlace, en nuestro Canal YouTube, donde podrás hacer consultas sobre el tema en directo.
¡Te esperamos!
Todo esto… y mucho más
Para ampliar la información sobre el tema, te invitamos a consultar los siguientes enlaces: